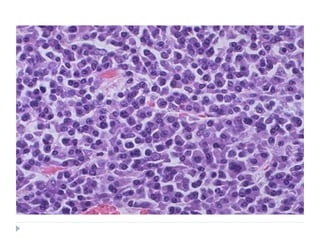
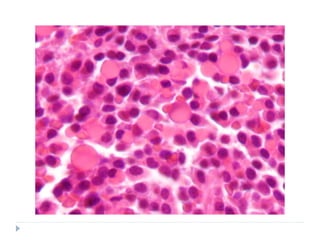

The document discusses several types of malignant connective tissue tumours. It describes fibrosarcoma, osteosarcoma, Hodgkin's lymphoma, Burkitt's lymphoma, Kaposi's sarcoma, plasmacytoma, and multiple myeloma. For each tumour, it covers etiology, clinical features such as presentation and location, histopathology, classification where relevant, and treatment options and prognosis. The document provides detailed information on characteristics and presentation of these malignant connective tissue tumours.